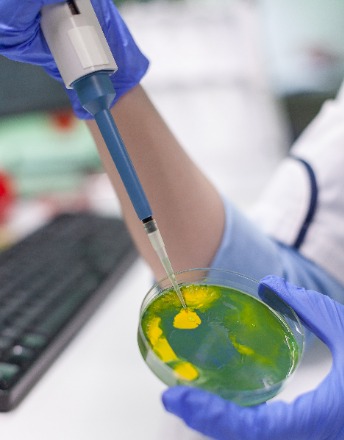

Loading
Archive
Recommended Articles
Drought treatment: A new tool for dissecting XA21 signaling in rice
Microbial infection can cause cell damage in both plants and animals, as well as triggering stress responses commonly induced by environmental (abiotic) cues.
Auditory system and COVID-19
The COVID-19 pandemic that emerged in 2020 may affect the peripheral and central auditory system. According to studies in the literature, symptoms affecting the vestibulocochlear system such as sudden hearing loss, tinnitus, and vestibular neuritis are seen in individuals with COVID -19.
Role of KIR like natural killer cell receptors in autoimmune disorders: A commentary
The significance of KIR like natural killer cell receptors in autoimmune disorders was published by us in the year 2020 in a reputed journal “Clinical Immunology”. In this issue we have discussed the complex nature of autoimmune diseases revealing a multi-factorial etiology that involves a combination of genetic and environmental factors
Microbiome to dictate the occurrence of neurological disorders
Neuropsychiatric disorders have been the constant burden impacting healthcare since 1990, and more than 3 billion people worldwide are living with neurological conditions. Mental health conditions with cognitive decline were also observed in people who contracted SARSCoV-2 and later presented the PACS related disease after the resolution of primary infection.
Phenotype-genotype discordance and disorders of sexual differentiation
Noninvasive Prenatal Testing (NIPT) and prenatal ultrasound can identify disorders of sexual differentiation (DSD), although discrepancies between genetic and phenotypic data can complicate diagnoses.
Understanding APOL1 and its role in end-stage renal disease: A comprehensive knowledge-based approach
The Apolipoprotein L1 gene (APOL1) has two risk variants crucial for innate immunity against pathogens, such as Trypanosoma and HIV. Still, it is also linked to diseases like preterm birth, pre-eclampsia, cardiovascular diseases, and systemic lupus erythematosus, which are often worsened by environmental factors or infections called "second hits."
Physics for the humanistic education of the doctor
We discuss why and how physics is an essential component of the human figure and the education of the doctor and surgeon, as a practitioner and as a man of science. An adequate general culture, and attention to historical and methodological dimensions, are the essential resources.
A comparative study of biological reactions to different suture materials in animal model
Sutures play an important role in wound healing. The search for more appropriate suture material has resulted in a variety of natural and synthetic, absorbable and non-absorbable sutures available commercially. These features influence biological reactions to the sutures.
Postmortem ant activity patterns in propofol anesthetic drug overdose
The recently reported case by Nagar et al. described extensive postmortem ant activity patterns in a propofol anesthetic drug overdose, mimicking antemortem traumatic injuries and posing a critical challenge for the forensic pathologist during postmortem examination, especially as the relatives of the deceased alleged foul play.
FEN1 drives small cell neuroendocrine carcinoma of the cervix progression and holds promise as a therapeutic target
Small cell neuroendocrine carcinoma of the cervix (SCNECC) is a rare and clinically aggressive subtype of cervical cancer associated with a poor prognosis. To investigate its underlying pathological mechanisms and identify potential therapeutic targets, researchers have increasingly employed single-omics or multi-omics integrated analysis, including single-cell transcriptome sequencing, proteomics, whole-exome sequencing, and genomics.
Cancer of unknown primary site (CUP), practice-changing diagnosis and therapy in the molecular era: a commentary
Cancer of unknown primary (CUP) is a clinicopathological syndrome of metastatic cancers without an identifiable anatomical primary site and has remained a diagnostic and treatment enigma for decades. Clinically occult primary tumor sites have been found by autopsies in about 75% of cases from more than twenty different sites [1], but some primaries are buried deep in tissues/organs and would require thousands of blind tissue sections to find.